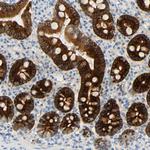
PIGR Antibody in Immunohistochemistry (Paraffin) (IHC (P))

Search
Invitrogen
PIGR Polyclonal Antibody
{{$productOrderCtrl.translations['antibody.pdp.commerceCard.promotion.promotions']}}
{{$productOrderCtrl.translations['antibody.pdp.commerceCard.promotion.viewpromo']}}
{{$productOrderCtrl.translations['antibody.pdp.commerceCard.promotion.promocode']}}: {{promo.promoCode}} {{promo.promoTitle}} {{promo.promoDescription}}. {{$productOrderCtrl.translations['antibody.pdp.commerceCard.promotion.learnmore']}}
产品信息
PA5-110769
种属反应
宿主/亚型
分类
类型
抗原
偶联物
形式
浓度
规格
纯化类型
保存液
内含物
保存条件
运输条件
RRID
产品详细信息
Immunogen sequence: LLFSVVINQL RLSDAGQYLC QAGDDSNSNK KNADLQVLKP EPELVYEDLR GSVTFHCALG PEVANVAKFL CRQSSGENCD VVVNTLGKRA PAFEGRILLN PQDKDGSFSV VITGLRKEDA GRYLCGAHS
Highest antigen sequence indentity to the following orthologs: Mouse - 65%, Rat - 67%.
靶标信息
Polymeric IgA and IgM is produced and secreted by B cells in the lamina propria, which is beneath the mucosal lining of polarized epithelial cells. Polymeric immunoglobulin receptors, also designated pIgRs, are expressed on the basolateral surface of glandular epithelia and mediate transcellular transport of secretory immunoglobulin polymers across the epithelium. pIgR associates with secreted dimeric IgA and IgM molecules. During transcellular transport of these Ig polymers, pIgR undergoes proteolytic cleavage to generate a fragment called secretory component (SC), polymeric immunoglobulin receptor or poly-IG receptor. When immunoglobulin polymers associate with SC, they become resistant to enzymatic degradation during the transcytosis process. SC and the pIgR are crucial for proper mucosal immunity where they represent a molecular chaperone for polymeric Igs to remain intact and enter into body fluids. The human SC (pIgR) gene maps to chromosome 1q31-q41 and encodes a 764 amino acid protein. The receptor contains five units with homology to the variable (V) units of immunoglobulins and a transmembrane region that shares homology to certain immunoglobulin variable regions.
仅用于科研。不用于诊断过程。未经明确授权不得转售。
篇参考文献 (0)
生物信息学
蛋白别名: hepatocellular carcinoma associated protein TB6; Hepatocellular carcinoma-associated protein TB6; PIgR; Poly Ig receptor; poly-Ig receptor; Polymeric immunoglobulin receptor; tb6
基因别名: PIGR
UniProt ID: (Human) P01833
Entrez Gene ID: (Human) 5284